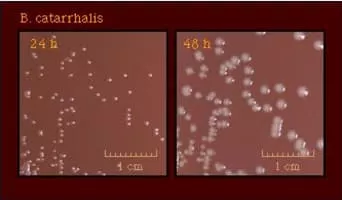

Moraxella
| Use attributes for filter ! | |
| Scientific name | Moraxella |
|---|---|
| Phylum | Proteobacteria |
| Order | Pseudomonadales |
| Rank | Genus |
| Higher classification | Moraxellaceae |
| Class | Gammaproteobacteria |
| Lower classifications | Moraxella catarrhalis |
| Moraxella osloensis | |
| Date of Reg. | |
| Date of Upd. | |
| ID | 2180630 |
About Moraxella
Moraxella is a genus of Gram-negative bacteria in the Moraxellaceae family. It is named after the Swiss ophthalmologist Victor Morax.